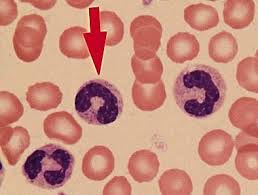
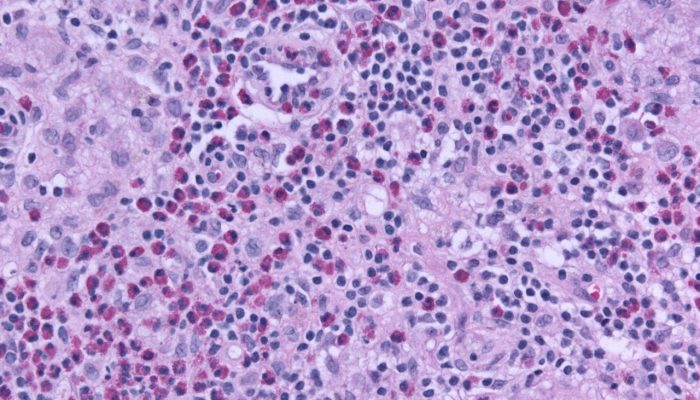

Основные функции
Лейкоциты крови – в первую очередь защитники организма, а такой их подвид как нейтроциты в основном занимается фагоцитозом, другими словами, уничтожением врагов – вирусов, бактерий и паразитарных микроорганизмов. Это и является основной функцией нейтрофилов.
Нейтрофилы крови в организме образуются в костном мозге, проживают в крови несколько часов и до нескольких суток в тканях. Такой короткий срок жизни этих клеток подразумевает, что процесс их обновления должен происходить непрерывно. И если организм борется с инфекцией, срок жизни нейтрофилов сокращается, так как, выполнив свою задачу, они самоуничтожаются. Очевидно, что эффективно борются с источниками инфекции только полноценные зрелые клетки. Такие нейтрофилы называются сегментоядерными, в норме их в мазке для анализа крови больше всего – до 70%.
Палочкоядерные нейтрофилы – это молодые клетки, их меньше, чем зрелых – от 1% до 6%. Совсем не должно быть в крови зачаточных форм нейтрофилов – миелоцитов и метамиелоцитов (их еще называют юными клетками), так как они не выходят из органов кроветворения, пока не пройдут до конца все стадии развития.
Баланс нарушается, если в организме происходит острый инфекционный процесс, и все защитные ресурсы мобилизуются для борьбы с ним – зрелые клетки быстро погибают, их срочно нужно заменять новыми, хотя они еще и не совсем готовы.
Увидеть процентное соотношение форм нейтрофилов в крови можно в развернутом анализе крови с лейкоцитарной формулой. Для отклонений от нормы, говоря о лейкоцитарной формуле, приняты понятия «сдвиг влево» и «сдвиг вправо». Что это означает?
Если распределить все стадии развития нейтрофила слева направо, это будет выглядеть так:
миелоцит – метамиелоцит (юный) – палочкоядерный – сегментоядерный
Когда за пределы нормы выходит количество молодых нейтрофилов в крови, формула сдвигается влево. И если выход за границы нормы происходит по количеству сегментоядерных зрелых форм – это сдвиг формулы вправо.
Причины повышения
Появление нейтрофилеза представляет собой особый механизм защиты организма от патогенных бактерий и вирусов, а также от распространения воспалительных процессов. Для точной диагностики заболеваний специалисты выделили три уровня превышения нейтрофилов у человека.
- Уровень не более 10×109/л указывает на умеренное повышение и наличие воспалительного процесса в организме.
- Показатель 10-20×109/л свидетельствует о выраженном превышении и наличии обширного воспаления в организме.
- Тяжелая степень определяется при показателях 20-60×109/л. Это требует срочного оперативного вмешательства, так как возможно развитие перитонита или сепсиса.
Самыми распространенными причинами повышенного содержания нейтрофилов в крови являются физиологические и патологические факторы.
Множество заболеваний человека сопровождаются повышением уровня нейтрофилов. Обследование крови не всегда выявляет точную причину, но значительно облегчает диагностику. К патологическим причинам относятся:
- Инфекции различных органов и систем (фурункулы, рожа, ринит, бронхит, дизентерия, тонзиллит, сальмонеллез, пиелонефрит, пневмония, цистит, менингит, энцефалит). При диагностике подобных заболеваний обязательно учитываются жалобы больного и сопутствующие симптомы, такие как повышение температуры тела, быстрое появление симптомов, болевой синдром, снижение иммунитета.
- Травмы (порезы, раны, растяжения, переломы, ожоги, последствия оперативных вмешательств).
- Вакцины. Повышение палочкоядерных нейтрофилов возможно после любой прививки. У детей подобное явление возникает после АКДС, БЦЖ, от полиомиелита, прививки против ротавируса и ветрянки.
- Отравления. Причиной могут быть отравления солями тяжелых металлов, ядами змей и насекомых, а также при вдыхании ядовитых газов. При подобной интоксикации важно вовремя обратиться за помощью, так как возможно развитие печеночной, почечной недостаточности и других серьезных осложнений.
- Патологии внутренних органов (инфаркт, мочекаменная болезнь, инсульт, холангит, холецистит). При опросе пациентов, выявляли хронические патологии, которые привели к подобному состоянию, они ощущали нестерпимую и постоянную боль, а также наблюдалось резкое ухудшение самочувствия. Обычно при подобных патологиях повышаются нейтрофилы и определяют низкие лимфоциты.
- Онкологические заболевания крови (лейкоз, миелолейкоз, лимфогранулематоз). Больные при этом страдают длительной лихорадкой и кровоточивостью десен, носовым и желудочным кровотечением. При данных патологиях нейтрофилы палочкоядерные повышены.
Физиологические причины не связаны с каким-либо заболеванием.
Повышение гранулоциртарного уровня может наблюдаться в следующих случаях:
- Потребление пищи. Вместе с ней в организм попадают микробы и бактерии, которые он должен обезвредить. Поэтому после еды наблюдается повышение сегментоядерных нейтрофилов или палочкоядерных.
- Курение. В состав сигарет входит большое количество веществ, токсинов и ядов, которые вызывают развитие воспалительных процессов. Чтобы их обезвредить увеличивается количество нейтрофилов.
- Лечение лекарственными препаратами. Многие принимают иммуномодуляторы в качестве профилактики и лечения, проходят вакцинацию. Именно эти компоненты влияют на количество гранулоцитов.
- Алкоголь. Этанол повреждает внутренние органы и может стать причиной развития воспалительного процесса.
- Интенсивные физические упражнения.
- Стресс и эмоциональные нагрузки.
Расшифровка результатов анализа
Результаты анализа оцениваются путем сравнения с нормальными значениями:
- У взрослых и детей старше 13 лет нормальное количество эозинофилов в мазке из носа составляет 0,5-5%, что соответствует 0,02-0,3 эозинофилам на 1 микролитр крови.
- У детей младше 13 лет норма немного выше и составляет 0,5-7%.
Степень выраженности аллергической реакции оценивается по количеству эозинофилов в мазке в сравнении с нормой:
- Если эозинофилы не обнаружены или обнаружен только 1 эозинофильный лейкоцит, что соответствует норме, то это может указывать на отсутствие активности аллергической реакции;
- Наличие 1,1-1,5 эозинофила у детей и взрослых может свидетельствовать о слабой активности такой реакции;
- 6-15 клеток указывают на среднюю активность;
- 16-20 эозинофильных лейкоцитов соответствуют высокой активности;
- Более 20 эозинофильных лейкоцитов в мазке указывают на очень высокую выраженность аллергии.
Увеличение количества эозинофилов называется эозинофилией.
Это может указывать на наличие следующих заболеваний и состояний:
- Аллергические заболевания кожи и респираторных путей, при которых количество эозинофилов увеличивается наиболее часто.
- Бронхиальная астма.
- Неаллергический эозинофильный ринит, причина возникновения которого неизвестна.
- Глистные заболевания (чаще вызванные аскаридами) и любые паразитарные болезни, вызываемые простейшими – такими, как лейшмании, лямблии, амебы; насекомыми, клещами и другими.
- Узелковый периартериит, который характеризуется поражением стенок мелких и средних артерий, сопровождающимся воспалением и некрозом. Чаще этому заболеванию неясной этиологии подвержены мужчины среднего возраста.
- Лейкемия. Сопровождается поражением сердечных клапанов, что ведет к быстрому развитию сердечной недостаточности. Чаще бывает у детей.
- Заболевания, обусловленные стафилококком, который, в частности, провоцирует развитие воспалительных заболеваний уха, горла и носа.
- Патология развития легких.
- Состояние иммунодефицита.
- Употребление некоторых лекарств.
Для получения максимально достоверных результатов процедуру взятия мазка из носа на эозинофилы повторяют через несколько дней. Эозинофилия не является заболеванием. Это клинический симптом, который наблюдается при различных заболеваниях или вызывается другими причинами и исчезает при излечении заболевания или устранении причин, вызвавших этот симптом.
Лечение
Какие медикаменты могут назначить?
Определение цели проведения анализов и последующего обследования пациентов должно осуществляться исключительно медицинским специалистом. После установления диагноза осуществляется комплексное лечение, направленное на устранение основного источника проблемы. В случае инфекционных, вирусных и грибковых заболеваний назначаются:
Во время стрессовых ситуаций и эмоциональных перегрузок:
При недостатке витаминов:
При интоксикации:
Диета
Не существует определенной диеты, которая может нормализовать показатели. Если у взрослого или ребенка повышены лимфоциты или уровень нейтрофилов повышен или понижен, важно придерживаться общих правил здорового и разумного питания.
Рекомендуется употреблять пищу небольшими порциями несколько раз в течение дня и исключить из рациона жирную, копченую, жареную и острую пищу, а также газированные напитки.
Приготовление пищи на пару является более предпочтительным. Важно, чтобы рацион включал в себя обильное количество фруктов, овощей, морепродуктов и натуральных соков.
Питьевой режим играет значительную роль. Регулярное употребление чистой, не газированной воды способствует поддержанию всех процессов, происходящих в организме.
Народные методы
Из средств народной медицины при состояниях, когда уровень нейтрофилов повышен или количество лимфоцитов снижено, наиболее эффективен настой липового цвета. Сырье заливают стаканом кипятка, настаивают и принимают в отфильтрованном виде трижды в день. Липа помогает бороться с простудой и другими заболеваниями, снижает температуру и укрепляет иммунитет.
Также применяют хвощ полевой. Он содержит в своем составе кремний, который уменьшает количество нейтрофилов.
Для этого используют сок свежего растения или отвар из высушенного сырья.
Нейтрофилы в мазке из носа
Привет. Как правило, наличие нейтрофилов в мазке из носа указывает на острой воспалительный процесс инфекционного происхождения в организме ребенка. Это может быть вызвано обсеменением слизистой оболочки носовых ходов бактериями, вирусами или грибковой патогенной микрофлорой. При таких параметрах риноцитограммы аллергическая реакция исключается, так как аллергический ринит или выделение большого количества слизистого секрета из носа обычно вызывают эозинофилы, несущие информацию для тучных клеток, и провоцируют запуск аллергической реакции путем выделения специальных веществ — гистаминов.
Таким образом, эозинофилы пытаются активировать естественную защитную реакцию иммунитета. Прием антигистаминных препаратов (например, "Супрастин", "Тавегил", "Кестин", "Кларитин") направлен на подавление работы эозинофилов. Если их активность отсутствует, то прием препаратов от аллергии нецелесообразен. Поэтому важно исключить такую возможность, так как данные методы лечения будут абсолютно неэффективны. Следует сконцентрироваться на выявлении патогенной микрофлоры в слизистых оболочках носа. Длительная бактериальная инфекция у детей может в конечном итоге привести к формированию аденоидита. Рекомендуется начать с взятия мазка из носа и зева для определения микрофлоры и ее чувствительности к этиотропному лечению.
Если в мазке не будет обнаружено бактериальной и грибковой микрофлоры, то следующим этапом будет анализ крови на вирусное носительство. И только после этого можно проводить адекватное лечение, направленное на устранение патогенной микрофлоры и восстановление иммунитета, включая местный иммунитет.
Норма клеток
Для определения уровня клеток в организме человека используется анализ крови, мазок из носа и зева. Иногда при длительном насморке бывает сложно выявить причину его возникновения, и в таких случаях проводится риноцитограма.
Исследование выполняется путем взятия соскоба с задней части нижней носовой пазухи, который затем окрашивается в различные тона. Уровень кровяных телец меняется в зависимости от вида аллергена, типа и стадии аллергической реакции. Показания к проведению исследования включают в себя отек слизистой, заложенность носа и подозрение на аллергические признаки воспаления в носовых пазухах.
Норма эозинофилов составляет от 1 до 5% от общего количества лейкоцитов или 0,02 – 0,3 клеток на 1 мкл крови. Уровень клеток не зависит от пола. У женщин в некоторых случаях наблюдается снижение нормы эозинофилов в крови, что происходит во время менструации: от начала овуляции до конца цикла, а перед началом месячных их количество, наоборот, немного повышается.
Уровень эозинофилов колеблется в течение 24 часов в зависимости от работы надпочечников. Утром и вечером уровень клеток становится ниже среднесуточного на 20%, а с полуночи до 3–4 часов – повышается на 30%. Поэтому рекомендуется сдавать анализы крови утром. В слизи и мокроте лейкоцитарные клетки содержатся в минимальных количествах.
Важно помнить, что перед сдачей мазка из носа на эозинофилы следует исключить использование назальных лекарственных препаратов с содержанием кортикостероидов за 24 часа.
Эозинофилы представляют собой вид иммунных клеток. Уровень клеток у детей меняется в зависимости от возраста. У грудничков это количество колеблется от 1 до 5%, от года до двух содержание незначительно изменяется и возрастает до 7%. Норма эозинофилов у детей от 4 до 18 лет приближается к показателям взрослых и составляет 1–5%.
В здоровом состоянии слизистую носовых пазух покрывает секрет, который способствует удалению пыли и микробов. При снижении иммунитета микроорганизмы активируются, что приводит к развитию воспалительного процесса и изменению слизистой. В результате ответа иммунной системы количество полезных клеток повышается или снижается. При показателе эозинофилов 0 у взрослого человека говорят о наличии серьезного инфекционного процесса.
Важно помнить, что использование лекарственных препаратов с кортикостероидами, антигистаминных средств может показать ложный результат.
Для повышения достоверности мазок повторяют через 2–3 дня. Если патологических изменений не выявлено, то норма эозинофилов у ребенка и взрослого человека не нарушается.
Разновидности насморка
Отклонения от нормы не всегда свидетельствуют о наличии какого-либо диагноза у малыша.
Для полноценной оценки соскоба врачу необходимо учесть результаты других анализов, а также выслушать жалобы малыша и его родителей. Наиболее точную картину помогут получить комплексные данные, включая аллергические пробы, посев и ПЦР-диагностику.
Тем не менее, существуют определенные особенности, характерные для различных заболеваний, которые можно выявить при анализе мазка из носовой полости:
- При бактериальной инфекции, вызывающей насморк у ребенка, в мазке обнаруживается большое количество слизи и разнообразных бактерий. Также возможно наличие большого количества нейтрофилов и клеток эпителия.
- Мазок из носовой полости у детей с вирусным насморком обычно содержит минимальное количество бактерий и лейкоцитов. Вместе с тем увеличивается количество лимфоцитов, которые защищают носовые ходы от вирусов. Также обычно выявляется повышенное количество клеток эпителия. Похожие изменения можно наблюдать при грибковой инфекции, что является важной информацией для опытного специалиста.
Повышенное количество лимфоцитов указывает на успешную борьбу организма с инфекцией.
-
Хронический насморк, который не прекращается в течение длительного времени, также отразится на анализе мазка. Количество нейтрофилов значительно увеличено – они могут составлять до 75% всего образца. Однако при острой форме насморка эти клетки обычно занимают еще большую площадь – до 85%. Также увеличено количество недифференцированных клеток (до 25%). Такое состояние объясняется тем, что организм длительное время подвергается воспалению слизистой, что приводит к изменению структуры клеток, делая их неузнаваемыми.
-
Аллергический насморк отразится на анализе мазка увеличенным содержанием эозинофилов, которые могут составлять от 10 до 75% всего объема. Также возможно увеличение базофилов и клеток плоского эпителия. При этом количество бактерий минимально или их вовсе нет. Если при таких результатах аллергические тесты отрицательные, то существует вероятность, что у пациента наблюдается неаллергический эозинофильный насморк.
-
Сложно диагностировать вазомоторный насморк. Как правило, у таких детей все показатели в мазке находятся в норме, за исключением незначительного увеличения количества эпителиальных клеток. Поэтому данный диагноз ставится методом исключения других вариантов. Вазомоторный насморк лечат в соответствии с рекомендациями отоларинголога и невролога.
Существуют и другие виды насморка, большинство из которых характеризуются отсутствием в мазке лейкоцитов – эозинофилов, базофилов. Помимо вазомоторного, существуют насморки, которые возникают из-за постоянного употребления сосудосуживающих препаратов, а также вследствие гормональных нарушений. Иногда насморк вызван стрессом, нарушением размера и формы носовых ходов.
Насморк может развиться из-за использования сосудосуживающих препаратов.
Повышение
Другое название данного состояния – нейтрофилия или нейтрофилёз.
Факторы, которые могут вызвать увеличение нейтрофилов:
- Инфекционные заболевания (вирусные, грибковые, бактериальные, паразитарные) — актуальные или недавно перенесенные;
- Воспалительные процессы;
- Повреждения тканей (включая послеоперационные состояния);
- Некрозы тканей (при инфарктах и инсультах, ожогах, гангренах);
- Отравления (пищевые, медикаментозные и другие);
- Сахарный диабет;
- Злокачественные опухоли
- Аллергические реакции;
- Применение определенных медицинских препаратов (гормональных);
Нейтрофилия может иметь различную степень, которую также можно определить по результатам анализа крови и сделать вывод, насколько тяжело протекает заболевание.
Значения, соответствующие степеням нейтрофилии:
- Умеренная степень – менее 10*109/л – в этом случае, вероятно, в организме протекает локализованный воспалительный процесс;
- Выраженная степень – от 10 до 20 *109/л – при таком значении показателя воспаление может быть более обширным;
- Тяжелая степень – от 20 до 60 *109/л – характерна для обобщенных состояний (сепсис крови, перитонит), в этом случае меняется не только количество, но и качество клеток, при тяжелой степени нейтрофилии гемограмма показывает значительный сдвиг влево.
Однако, существует такое понятие как физиологическая нейтрофилия – это незначительное увеличение количества нейтрофилов у здоровых людей вследствие недавно перенесенных физических или эмоциональных нагрузок, а также во время беременности. В последнем случае нагрузка на нейтрофилы в организме женщины увеличивается, ведь им приходится справляться с возросшим количеством токсинов, поступающих в кровь. Во время беременности контроль уровня нейтрофилов особенно важен – значительное увеличение показателя может свидетельствовать, например, об угрозе выкидыша.
Результаты
Понимание данных цитологического исследования необходимо в контексте других признаков заболевания. Для получения более достоверных результатов рекомендуется повторить анализ через несколько дней. После получения отчета с указанными показателями, врач производит их оценку с учетом нормативных значений. И лишь после этого он может сделать соответствующие выводы.
Норма
При анализе мазка из носа на содержание эозинофилов, норма клеток зависит от возраста. У детей до 13 лет это значение не должно превышать 7%, а у более старших детей и взрослых – 5%. Минимальное значение находится на уровне 0,5%. Однако риноцитология способна выявить и другие клеточные элементы (см. таблицу №1):
Но важно отметить, что референтные значения могут различаться в зависимости от того, откуда был взят образец.
Поэтому при проведении анализа важно придерживаться установленной методики. Каждая лаборатория (Синэво, Инвитро и другие) указывает стандартные значения в отчете рядом с фактическими.
И пациент, так же, как и врач, может их сопоставить.
Нормальные показатели цитологии свидетельствуют об отсутствии изменений в слизистой оболочке. Однако наличие клинических симптомов должно послужить основанием для повторного проведения анализа.
Повышение
Увеличение количества клеточных компонентов в мазке указывает на наличие патологического процесса, затрагивающего слизистую оболочку носа. По характеру отклонений от нормы можно сделать вывод о возможных причинах нарушений.
Эозинофилы
Если у ребенка или взрослого обнаружено более 10% эозинофилов, то это может указывать на аллергический насморк. Однако подобное явление часто наблюдается и при других заболеваниях с признаками нарушений иммунной системы:
- Эозинофильный ринит (полипоз).
- Узелковый периартериит.
- Лейкозы.
- Глистные инвазии.
Кроме того, только наличие эозинофилии недостаточно для подтверждения аллергического насморка. Обычно требуется провести дополнительное обследование с общим анализом крови (в котором также возрастают эозинофилы) и определением уровня иммуноглобулинов. Часто необходимо выявить конкретный антиген, вызвавший аллергическую реакцию (аллергопробы).
Следует отметить, что уровень эозинофилов в выделениях коррелирует с тяжестью патологического процесса. Кроме того, аллергическая реакция сопровождается параллельным ростом базофилов и тучных клеток. Эта зависимость отражена в таблице №2:
Нейтрофилы
Наличие большого количества нейтрофилов в организме указывает на наличие инфекционного процесса. Эти клетки являются первыми, которые приходят в очаг воспаления, поэтому они характерны для острой формы насморка. При хроническом насморке их количество снижается, но остается выше нормы. Обычно это свидетельствует о бактериальном поражении слизистой оболочки, но также вирусные инфекции могут вызывать увеличение числа нейтрофилов.
Лимфоциты
Лимфоцитарная инфильтрация слизистой оболочки носа является типичной для острой вирусной инфекции и длительного насморка. Хронический насморк часто сопровождается гипер- или атрофическими изменениями. Продолжительное воспаление обязательно вызывает реакцию со стороны лимфоцитов, так как они играют важную роль в местной защите. Однако их количество увеличивается не так быстро, как количество нейтрофилов.
Эритроциты
Когда результат мазка на цитологию показывает наличие эритроцитов, это может указывать на увеличение проницаемости сосудистой стенки или более серьезные повреждения слизистой оболочки. Такое явление возможно при гриппе, дифтерии, атрофическом рините (озене) или язвенном поражении носа. В таких случаях необходимо провести более тщательную диагностику.
Увеличение клеточных элементов в риноцитограмме может свидетельствовать о наличии патологического процесса аллергического или воспалительного характера.
Понижение
Если анализ показывает уменьшение форменных элементов в назальном секрете, то следует рассмотреть другие причины насморка. Вероятно, воспалительные и аллергические процессы не являются источником симптомов, и стоит обратить внимание на вазомоторный (нейрорефлекторный) ринит, возникающий из-за неправильного применения сосудосуживающих капель, при гормональных и психоэмоциональных нарушениях, а также аномалиях носовых ходов.
Риноцитограмма играет важную роль в диагностике насморка. Определение эозинофилов в мазке позволяет с высокой степенью достоверности предположить аллергическую природу ринита. Однако врач не ограничится только анализом слизи из носа, и, вероятно, назначит пациенту дополнительные исследования для уточнения характера процесса. Ведь от правильности диагноза зависит эффективность лечения.
Что такое эозинофилы и их норма в организме
Формирование эозинофилов занимает от 72 до 96 часов, после чего они выходят из костного мозга и циркулируют по артериям, венам и капиллярам в течение 6–20 часов.
Средний срок жизни эозинофилов составляет около двух недель. Они перемещаются из крови в пищеварительную систему, дыхательные органы, кожу и остаются там до своего естественного распада.
Отметим, что эозинофилы играют важную роль в организме.
Они выполняют несколько функций:
- в борьбе с паразитическими червями;
- в нейтрализации чужеродных клеток.
Для определения содержания эозинофилов в крови необходимо провести общий анализ крови.
Иногда для оценки количества и функциональности эозинофилов используется секрет из носоглотки. Для этого берется мазок из носа.
Нормальное содержание эозинофилов в крови немного различается у детей и взрослых. До 13 лет значение может варьироваться от 0,5 до 7%, а для взрослых — от 0,5 до 5%.
При проведении анализа на эозинофилы из носа их концентрация должна стремиться к нулю.
Повышенное содержание эозинофилов может быть признаком развития синдрома воспаленной слизистой – ринита.
Мазок на эозинофилы позволяет ЛОР-врачу отличить аллергический насморк от инфекционного.
Высокое содержание эозинофилов в крови может указывать на развитие респираторной чувствительности к аллергенам или бронхиальной астмы. Также это может быть признаком наличия аскарид в организме.
Повышенное содержание эозинофилов в мазке из носа называется эозинофилией.
Это состояние может указывать на развитие серьезных заболеваний:
- аллергии, которая может сопровождаться заболеваниями кожи и дыхательных путей;
- узелкового периартериита, характеризующегося воспалением и разрушением артерий мышечного типа;
- лейкемии, поражающей сердечные клапаны;
- паразитарной инвазии.
Своевременный анализ с помощью мазка из носа позволяет выявить отклонения от нормы и начать лечение.
Увеличение нормы
Повышенные уровни эозинофилов указывают на наличие воспаления, и чем выше этот показатель, тем серьезнее заболевание. Существует несколько степеней эозинофилии: легкая – увеличение до 10%; умеренная – 10-15%; выраженная – свыше 15%.
Если эозинофилы увеличены в анализе крови, это может свидетельствовать о наличии острых аллергических проявлений, бронхиальной астмы, злокачественных опухолей, гельминтов или аллергического насморка.
При аллергии на организм воздействуют разнообразные раздражители, что приводит к повышенной чувствительности иммунной системы. В результате слизистая выделяет определенные вещества, которые провоцируют симптомы аллергической реакции.
Вазомоторный ринит вызывает отек слизистой и изменение тонуса кровеносных сосудов в носу. Повышенный уровень эозинофилов в мокроте также указывает на патологию легких, болезнь Лефлера или наличие гельминтов.
Когда у грудничка повышены эозинофилы, причиной этого может быть аллергическая реакция на коровье молоко или лекарственные препараты, внутриутробная инфекция, пемфигус новорожденных, атопический дерматит или эозинофильный конфликт.
У детей до трех лет возможно проявление наследственной эозинофилии в виде инфильтратов в легких и приступов астматического бронхита. Первичный эозинофилийный синдром в таком возрасте практически не встречается. В случае реактивной формы болезни назначается лечение основного заболевания, в результате чего уровень лейкоцитарных клеток нормализуется. Если у ребенка старше трех лет повышены эозинофилы, возможны острицы, бронхиальная астма, аллергический ринит, инфекционные болезни, кожный дерматит, аллергии различной этиологии или онкогематология.
В некоторых случаях лабораторные исследования могут показать ложные результаты. При показателе выше нормы рекомендуется провести дополнительные анализы. Повышенный уровень кровяных телец говорит о воспалительном процессе в организме, поэтому не стоит откладывать лечение – это может привести к серьезным осложнениям.
Риноцитограмма что это такое
Риноцитограмма – это способ выявления заболеваний носоглотки путем анализа клеточного состава (цитологии) мазка из носа.
Слизистая оболочка носовых полостей и пазух состоит из разнообразных типов клеток. Некоторые из них выделяют слизистую жидкость, которая выполняет защитную и дренажную функции. Проникновение патогенов (грибков, бактерий или вирусов) вызывает воспаление тканей и активацию иммунных клеток – лейкоцитов.
Вирусный, аллергический и бактериальный ринит вызывает отечность слизистой носа и обильное выделение слизи. В очаге воспаления при этом обильно присутствуют элементы крови, обеспечивающие гуморальный и клеточный иммунитет. Мазок из пораженных носовых полостей и анализ взятой пробы биоматериала позволяют определить соотношение лейкоцитов различных типов, увидеть отшелушившийся эпителий и сделать вывод о причинах продолжительного насморка.
При инфекции носоглотки вызванной бактериями или осложненной вирусом, риноцитограмма может выявить наличие бактерий, в основном кокков.
Многих людей интересует, насколько процедура болезненна и сколько времени занимает анализ. Риноцитограмма абсолютно безболезненна: местная анестезия требуется только при взятии проб из носовых синусов с помощью эндоскопа. В большинстве лабораторий исследование и расшифровка занимают не более 1-2 дней.
Микроскопическое исследование отделяемого носа риноцитограмма
Если в мазке отсутствуют лейкоциты (включая эозинофилы, нейтрофилы и другие) или их количество очень мало, это может указывать на наличие вазомоторного ринита.
https://youtube.com/watch?v=jnHwQ72xQvE
Частые вопросы
Какую роль играют эозинофилы в мазке из носа?
Эозинофилы в мазке из носа играют важную роль в иммунной системе, так как они являются ключевыми клетками в борьбе с аллергическими реакциями и воспалением.
Какие заболевания могут быть связаны с повышенным уровнем эозинофилов в мазке из носа?
Повышенный уровень эозинофилов в мазке из носа часто связан с аллергическими ринитами, атопическими заболеваниями и другими воспалительными процессами в дыхательных путях.
Какие методы лечения используются для снижения уровня эозинофилов в мазке из носа?
Для снижения уровня эозинофилов в мазке из носа могут применяться антигистаминные препараты, глюкокортикостероиды, десенсибилизация и другие методы, направленные на уменьшение аллергических реакций и воспаления.
Полезные советы
СОВЕТ №1
Если у вас обнаружены повышенные уровни эозинофилов в мазке из носа, обратитесь к врачу-оториноларингологу для проведения дополнительного обследования и уточнения диагноза.
СОВЕТ №2
Избегайте контакта с аллергенами, которые могут вызывать реакцию эозинофилов, такими как пыль, пыльца, плесень, домашние животные и др. Регулярная уборка помещения и использование специальных фильтров может помочь снизить уровень аллергенов.